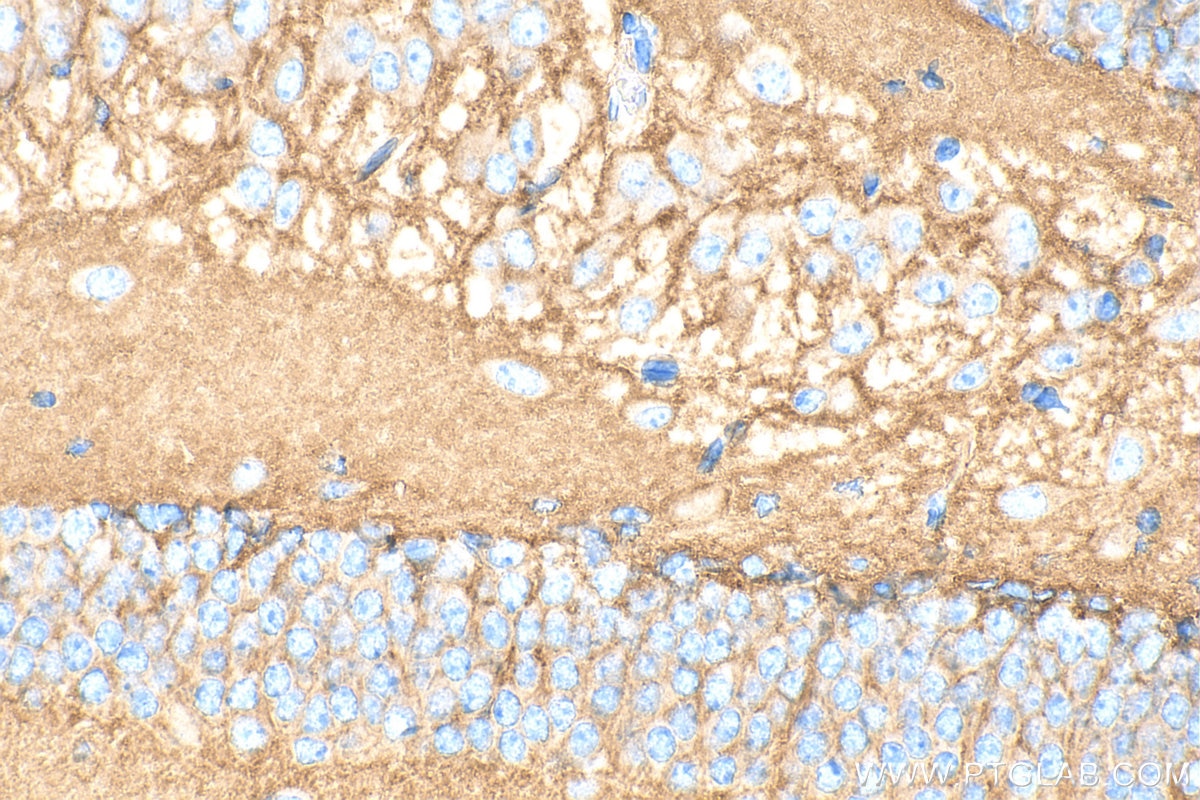
Immunohistochemistry (IHC) staining of mouse brain tissue using TrkB Polyclonal antibody (33093-1-AP)

Tested Applications
| Positive WB detected in | mouse brain tissue, rat brain tissue |
| Positive IHC detected in | mouse brain tissue Note: suggested antigen retrieval with TE buffer pH 9.0; (*) Alternatively, antigen retrieval may be performed with citrate buffer pH 6.0 |
| Positive IF-P detected in | mouse brain tissue |
Recommended dilution
| Application | Dilution |
|---|---|
| Western Blot (WB) | WB : 1:1000-1:4000 |
| Immunohistochemistry (IHC) | IHC : 1:200-1:800 |
| Immunofluorescence (IF)-P | IF-P : 1:50-1:500 |
| It is recommended that this reagent should be titrated in each testing system to obtain optimal results. | |
| Sample-dependent, Check data in validation data gallery. | |
Product Information
33093-1-AP targets TrkB in WB, IHC, IF-P, ELISA applications and shows reactivity with mouse, rat samples.
| Tested Reactivity | mouse, rat |
| Host / Isotype | Rabbit / IgG |
| Class | Polyclonal |
| Type | Antibody |
| Immunogen |
CatNo: Eg3000 Product name: Recombinant Mouse TrkB protein (rFc Tag) (HPLC verified) Source: mammalian cells-derived, V37 Tag: C-rFc Domain: 32-429 aa of NM_001025074.3 Sequence: CPTSCKCSSARIWCTEPSPGIVAFPRLEPNSVDPENITEILIANQKRLEIINEDDVEAYVGLRNLTIVDSGLKFVAYKAFLKNSNLRHINFTRNKLTSLSRRHFRHLDLSDLILTGNPFTCSCDIMWLKTLQETKSSPDTQDLYCLNESSKNMPLANLQIPNCGLPSARLAAPNLTVEEGKSVTLSCSVGGDPLPTLYWDVGNLVSKHMNETSHTQGSLRITNISSDDSGKQISCVAENLVGEDQDSVNLTVHFAPTITFLESPTSDHHWCIPFTVRGNPKPALQWFYNGAILNESKYICTKIHVTNHTEYHGCLQLDNPTHMNNGDYTLMAKNEYGKDERQISAHFMGRPGVDYETNPNYPEVLYEDWTTPTDIGDTTNKSNEIPSTDVADQSNREH Predict reactive species |
| Full Name | neurotrophic tyrosine kinase, receptor, type 2 |
| Calculated Molecular Weight | 92 kDa |
| Observed Molecular Weight | 90-95 kDa, 140-145 kDa |
| GenBank Accession Number | NM_001025074.3 |
| Gene Symbol | Ntrk2 |
| Gene ID (NCBI) | 18212 |
| Conjugate | Unconjugated |
| Form | Liquid |
| Purification Method | Antigen affinity Purification |
| UNIPROT ID | P15209-1 |
| Storage Buffer | PBS with 0.02% sodium azide and 50% glycerol, pH 7.3. |
| Storage Conditions | Store at -20°C. Stable for one year after shipment. Aliquoting is unnecessary for -20oC storage. 20ul sizes contain 0.1% BSA. |
Background Information
Tropomyosin-related kinase B (TrkB) is a member of the neurotrophic tyrosine receptor kinase (NTRK) family. TrkB is primarily expressed in the central and peripheral nervous systems. TrkB plays an important role in neural development and maintenance through regulating neuronal differentiation, proliferation, survival, migration, neurogenesis, and plasticity.
Protocols
| Product Specific Protocols | |
|---|---|
| IF protocol for TrkB antibody 33093-1-AP | Download protocol |
| IHC protocol for TrkB antibody 33093-1-AP | Download protocol |
| WB protocol for TrkB antibody 33093-1-AP | Download protocol |
| Standard Protocols | |
|---|---|
| Click here to view our Standard Protocols |